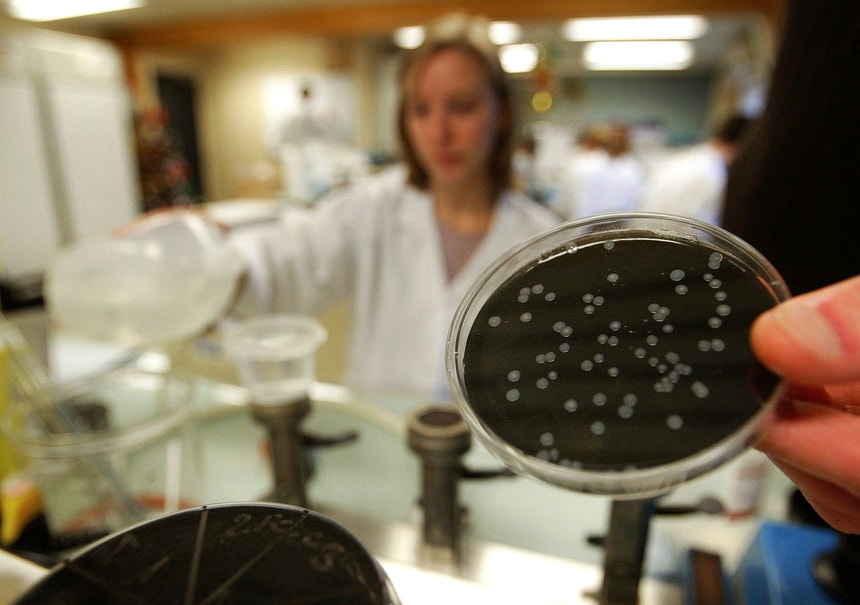

Saúde
Francisco George confirma caso de legionella
Pelo menos um trabalhador de uma fábrica na Maia, distrito do Porto, foi infetado pela bactéria. Em declarações à Antena 1, o diretor geral da Saúde, Francisco George, explicou que existem ainda outros sete casos em estudo.
O caso confirmado de legionella e os sete casos suspeitos foram todos diagnosticados nas últimas semanas.
A situação já motivou críticas por parte do presidente da Câmara Municipal da Maia que considerou inaceitável que a Direção Geral de Saúde não tivesse alertado a autarquia.
O município da Maia pretendia acionar meios para proteger a população.